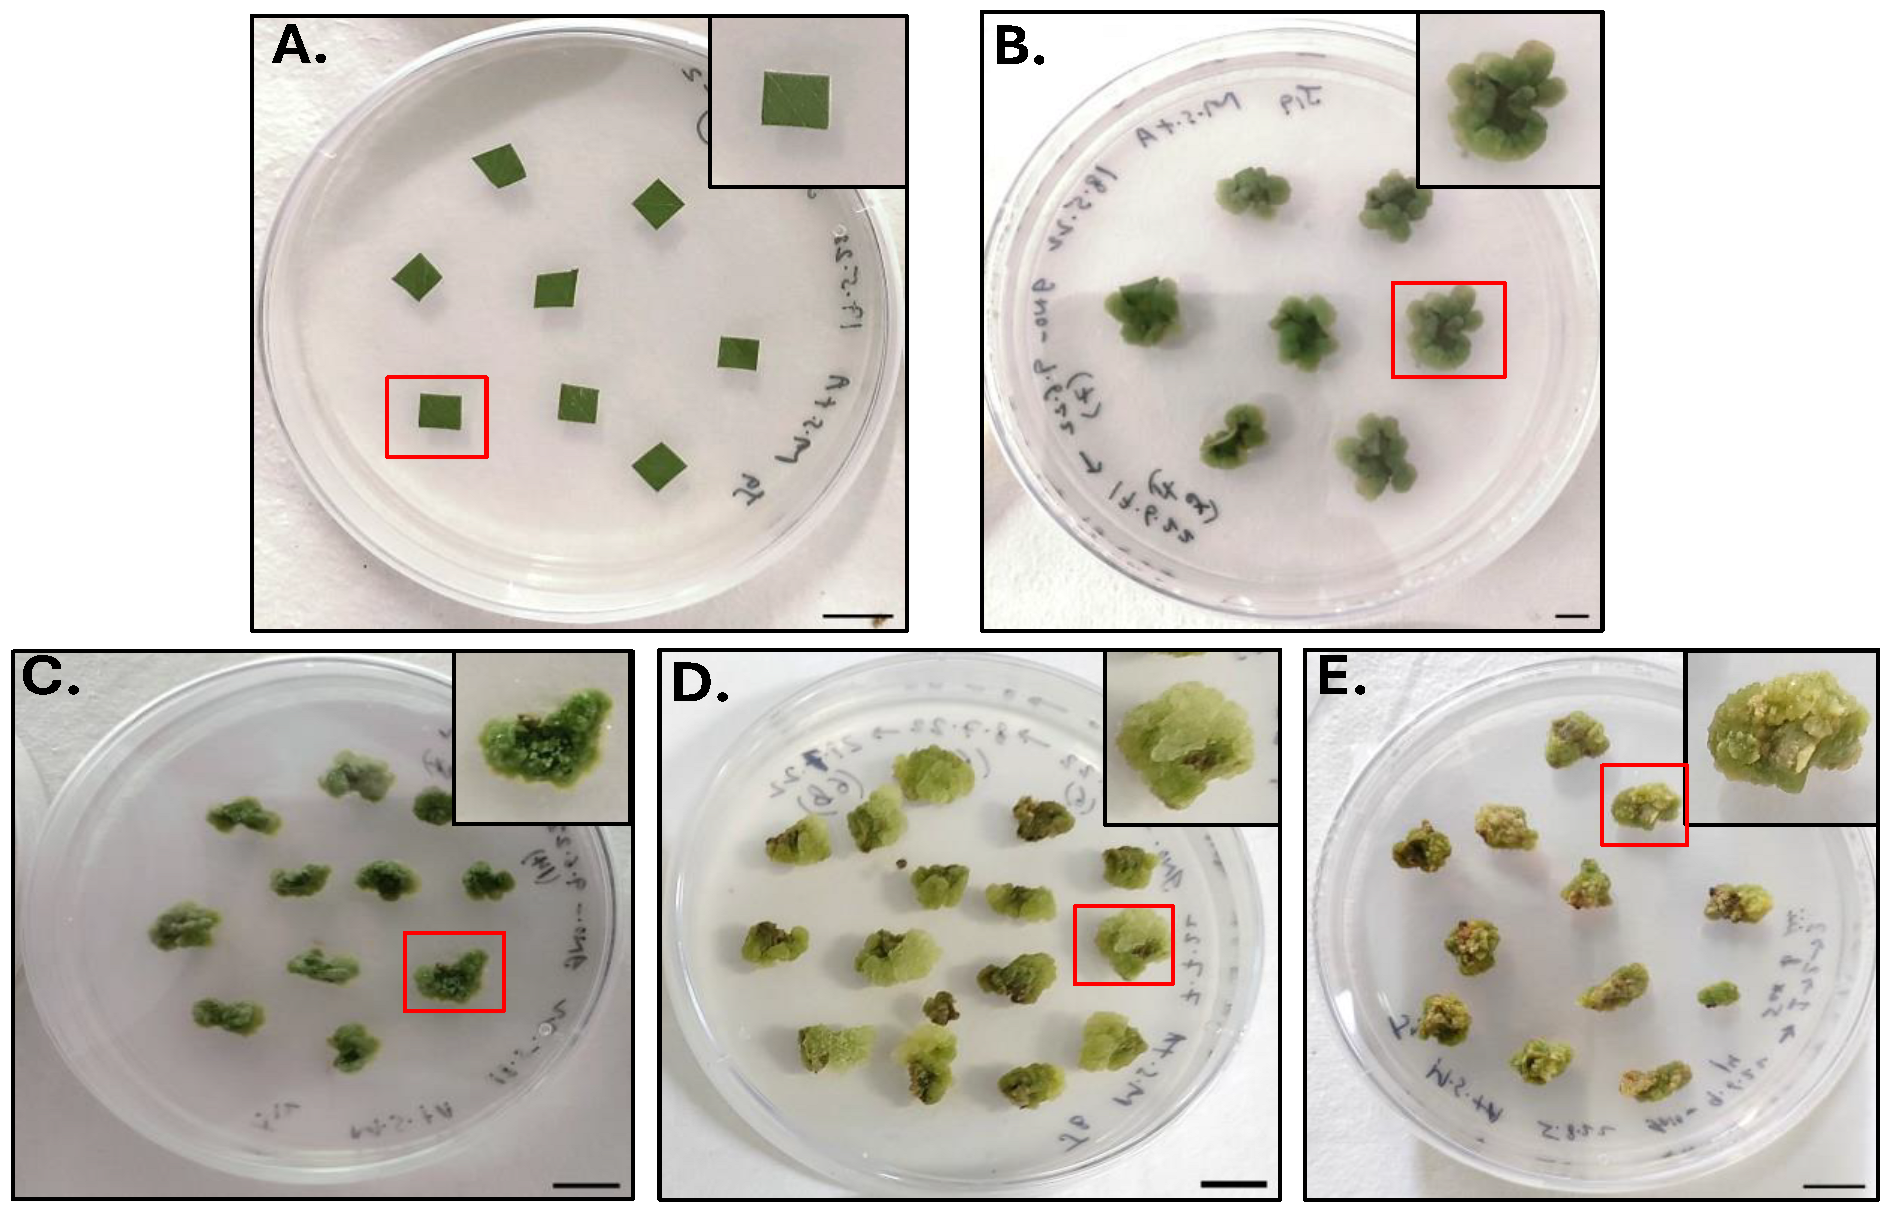
Molecules 30 03531 g001

Establishment of Callus Cultures from Dalbergia sissoo Leaf Explants for Production of Skin Therapeutics: An In Vitro and In Silico Study
Abstract
1. Introduction
2. Results and Discussion
2.1. Callus Culture Initiation
2.2. Antioxidant Potential Assay
2.3. Analysis of GC-MS Chromatograms
2.4. In Silico Analysis
2.4.1. ADME Predictions
2.4.2. Molecular Docking Analysis
2.5. Molecular Dynamics Simulation Studies
3. Materials and Methods
3.1. Chemicals and Reagents
3.2. Media Preparation
3.3. Establishment of Callus Culture
3.3.1. Plant Collection and Inoculation
3.3.2. Subculture Protocol
3.4. Extract Preparation
3.5. Antioxidant Assay
3.6. GC-MS Analysis
3.7. In Silico Analysis of Shortlisted Compounds
3.7.1. Drug Likeness (ADME Analysis)
3.7.2. Molecular Docking Study
Target Protein Preparation
Ligand Preparation
Molecular Docking
3.8. Molecular Dynamics Simulation (MDS)
3.9. Statistical Analysis
4. Conclusions
Supplementary Materials
Author Contributions
Funding
Institutional Review Board Statement
Informed Consent Statement
Data Availability Statement
Acknowledgments
Conflicts of Interest
References
- Dixit, S.; Rana, S. Investigation of immunomodulation activity in the leaves of Dalbergia sissoo. Glob. J. Pharm. Pharm. Sci. 2018, 5, 555655. [Google Scholar] [CrossRef]
- Hossen, M.F.; Nijhu, R.S.; Khatun, A. A phytochemical and pharmacological review on Dalbergia sissoo: A potential medicinal plant. J. Pharmacogn. Phytochem. 2023, 12, 52–57. [Google Scholar] [CrossRef]
- Vats, S.; Kaushal, C.; Timko, M.P.; Ganie, S.A. Uraria picta: A review on its ethnobotany, bioactive compounds, pharmacology and commercial relevance. S. Afr. J. Bot. 2024, 167, 333–354. [Google Scholar] [CrossRef]
- Sasidharan, S.; Chen, Y.; Saravanan, D.; Sundram, K.M.; Latha, L.Y. Extraction, isolation and characterization of bioactive compounds from plants’ extracts. Afr. J. Tradit. Complement. Altern. Med. 2011, 8, 1–10. [Google Scholar] [CrossRef]
- Cavinato, M.; Waltenberger, B.; Baraldo, G.; Grade, C.V.C.; Stuppner, H.; Jansen-Dürr, P. Plant extracts and natural compounds used against UVB-induced photoaging. Biogerontology 2017, 18, 499–516. [Google Scholar] [CrossRef]
- Buranasudja, V.; Rani, D.; Malla, A.; Kobtrakul, K.; Vimolmangkang, S. Insights into antioxidant activities and anti-skin-aging potential of callus extract from Centella asiatica (L.). Sci. Rep. 2021, 11, 13459. [Google Scholar] [CrossRef] [PubMed]
- Park, S.H.; Yi, Y.S.; Kim, M.Y.; Cho, J.Y. Antioxidative and Antimelanogenesis effect of Momordica charantia methanol extract. Evid.-Based Complement. Altern. Med. 2019, 2019, 5091534. [Google Scholar] [CrossRef]
- Budzianowska, A.; Banaś, K.; Budzianowski, J.; Kikowska, M. Antioxidants to defend healthy and youthful skin—Current trends and future directions in cosmetology. Appl. Sci. 2025, 15, 2571. [Google Scholar] [CrossRef]
- Tang, K.; Jiang, Y.; Zhang, H.; Huang, W.; Xie, Y.; Deng, C.; Xu, H.; Song, X.; Xu, H. Design, synthesis of cinnamyl-paeonol derivatives with 1, 3-dioxypropyl as link arm and screening of tyrosinase inhibition activity in vitro. Bioorg. Chem. 2021, 106, 104512. [Google Scholar] [CrossRef]
- Kooltheat, N.; Tedasen, A.; Yamasaki, K.; Chatatikun, M. Melanogenesis inhibitory activity, chemical components and molecular docking studies of Prunus cerasoides Buch.-Ham. D. Don. Flowers. J. Evid. Based Integr. Med. 2023, 28. [Google Scholar] [CrossRef]
- Ghasemi, N.; Moradi, S.; Iraji, A.; Mahdavi, M. Thiazolopyrimidine derivatives as novel class of small molecule tyrosinase inhibitor. BMC Chem. 2023, 17, 156. [Google Scholar] [CrossRef]
- Sadeghian, S.; Zare, F.; Khoshneviszadeh, M.; Hafshejani, A.F.; Salahshour, F.; Khodabakhshloo, A.; Saghaie, L.; Goshtasbi, G.; Sarikhani, Z.; Poustforoosh, A.; et al. Synthesis, Biological Evaluation, Molecular Docking, MD Simulation and DFT Analysis of New 3-Hydroxypyridine-4-One Derivatives as Anti-Tyrosinase and Antioxidant Agents. Heliyon 2024, 10, e35281. [Google Scholar] [CrossRef]
- Hassan, M.; Ashraf, Z.; Abbas, Q.; Raza, H.; Seo, S.Y. Exploration of novel human tyrosinase inhibitors by molecular modeling, docking and simulation studies. Interdiscip. Sci. 2018, 10, 68–80. [Google Scholar] [CrossRef]
- De Oliveira, D.R.; Da Silva, M.R.; Chaves, O.A.; Castro, R.N.; De Oliveira, M.C.C.; Braz-Filho, R.; De Carvalho, M.G. Phytochemical profile of Cespedesia spathulata leaves (ochnaceae) and its effect on tyrosinase enzyme. Acad. Bras. Cienc. 2021, 93, e20200443. [Google Scholar] [CrossRef] [PubMed]
- Zhao, Z.; Liu, G.; Meng, Y.; Tian, J.; Chen, X.; Shen, M.; Li, Y.; Li, B.; Gao, C.; Wu, S.; et al. Synthesis and anti-tyrosinase mechanism of the substituted vanillyl cinnamate analogues. Bioorg. Chem. 2019, 93, 100316. [Google Scholar] [CrossRef]
- Arroo, R.R.J.; Sari, S.; Barut, B.; Özel, A.; Ruparelia, K.C.; Şöhretoğlu, D. Flavones as tyrosinase inhibitors: Kinetic studies in vitro and in silico. Phytochem. Anal. 2020, 31, 314–321. [Google Scholar] [CrossRef]
- Barbieri, R.; Coppo, E.; Marchese, A.; Daglia, M.; Sobarzo-Sánchez, E.; Nabavi, S.F.; Nabavi, S.M. Phytochemicals for human disease: An update on plant-derived compounds antibacterial activity. Microbiol. Res. 2017, 196, 44–68. [Google Scholar] [CrossRef]
- Chen, S.L.; Yu, H.; Luo, H.M.; Wu, Q.; Li, C.F.; Steinmetz, A. Conservation and sustainable use of medicinal plants: Problems, progress, and prospects. Chin. Med. 2016, 11, 37. [Google Scholar] [CrossRef] [PubMed]
- Hasnain, A.; Naqvi, S.A.H.; Ayesha, S.I.; Khalid, F.; Ellahi, M.; Iqbal, S.; Hassan, M.Z.; Abbas, A.; Adamski, R.; Markowska, D.; et al. Plants in vitro propagation with its applications in food, pharmaceuticals and cosmetic industries; current scenario and future approaches. Front. Plant Sci. 2022, 13, 1009395. [Google Scholar] [CrossRef]
- Chandran, H.; Meena, M.; Barupal, T.; Sharma, K. Plant tissue culture as a perpetual source for production of industrially important bioactive compounds. Biotechnol. Rep. 2020, 26, e00450. [Google Scholar] [CrossRef] [PubMed]
- Krasteva, G.; Georgiev, V.; Pavlov, A. Recent applications of plant cell culture technology in cosmetics and foods. Eng. Life Sci. 2021, 21, 68–76. [Google Scholar] [CrossRef]
- Vitchit, W.; Saewan, N. Anti-oxidant and anti-aging activities of callus culture from three rice varieties. Cosmetics 2022, 9, 79. [Google Scholar] [CrossRef]
- Elbouzidi, A.; Taibi, M.; Baraich, A.; Haddou, M.; Mothana, R.A.; Alsufyani, S.A.; Darwish, H.W.; Molinié, R.; Fontaine, J.X.; Fliniaux, O.; et al. Elicitor-driven enhancement of phenolic compounds in geranium callus cultures: Phytochemical profiling via LC-MS/MS and biological activities. Front. Chem. 2025, 13, 1537877. [Google Scholar] [CrossRef] [PubMed]
- De Morais, D.V.; De Carvalho Costa, M.A.P.; Bárbara, M.F.S.; De Lima Silva, F.; Moreira, M.M.; Delerue-Mato, C.; Dias, L.A.G.; Estevinho, M.L.M.; De Carvalho, C.A.L. Antioxidant, photoprotective and inhibitory activity of tyrosinase in extracts of Dalbergia ecastaphyllum. PLoS ONE 2018, 13, e0207510. [Google Scholar] [CrossRef] [PubMed]
- Prakash Dahiya, D.; Sharma, A.; Sankhyan, A.; Kumari, R.; Thakur, S. Dalbergia sissoo: A boon to mankind. J. Med. Plants Stud. 2025, 13, 265–274. [Google Scholar]
- Kumari, K.; Kaushal, C.; Yadav, J.; Kumari, R.; Bhandari, N. Foliage of Dalbergia sissoo Roxb.: A potential antioxidant agent. PhytoTalks 2025, 1, 16–20. [Google Scholar] [CrossRef]
- Devi, P.; Singh, S.; Parvesh Devi, C. Phytochemical and pharmacological profiling of Dalbergia sissoo roxb. stem. J. Pharmacogn. Phytochem. 2017, 6, 2483–2486. [Google Scholar]
- Ali, I.; Rizwani, G.H.; Rasheed, M.; Ali, M.; Hassan, A.; Hassan, S.; Ishrat, G.; Zaheer, E.; Hussain, K.; Rehman, S. Chemical analysis of Dalbergia sissoo (Roxb.) Pod Oil by (GC-MS)/GC-FID and evaluation of antioxidant potential. Pak. J. Pharm. Sci. 2019, 32, 2175–2181. [Google Scholar]
- Yasmeen, S.; Gupta, P. Cosmeceutical and anticancer potential of aqueous extracts of Dalbergia sissoo Roxb. Aerial Parts. J. Herb. Med. 2021, 29, 100456. [Google Scholar] [CrossRef]
- El-Azzazy, E.; Ibrahim, M.; Reda, M. LC/MS profile and biological evaluation of Dalbergia sissoo growing in Egypt Desert. Azhar Int. J. Pharm. Med. Sci. 2024, 4, 159–168. [Google Scholar] [CrossRef]
- Vanshita; Bajpai, M. Phytochemistry and pharmacology of Dalbergia sissoo Roxb. Ex DC: A Review. J. Pharm. Pharmacol. 2023, 75, 482–501. [Google Scholar]
- Rana, A.S.; Pathak, H.; Verma, A.K.; Dubey, A. Physiological and biochemical responses of Dalbergia sissoo to environmental stressors: Implications for tree mortality and health. Biocatal. Agric. Biotechnol. 2025, 67, 103638. [Google Scholar] [CrossRef]
- Ali, A.; Rizwan, M.; Majid, A.; Saleem, A.; Naveed, N.H. Effect of media type and explants source on micropropagation of Dalbergia sissoo: A tree of medicinal importance. J. Med. Plants Res. 2012, 6, 1742–1751. [Google Scholar] [CrossRef]
- Liu, X.; Zhao, Y.; Chen, X.; Dong, L.; Zheng, Y.; Wu, M.; Ding, Q.; Xu, S.; Ding, C.; Liu, W. Establishment of Callus Induction System, Histological Evaluation and Taxifolin Production of Larch. Plant Cell Tissue Organ Cult. (PCTOC) 2021, 147, 467–475. [Google Scholar] [CrossRef]
- Sagharyan, M.; Ganjeali, A.; Cheniany, M.; Kouhi, S.M.M. Optimization of callus induction with enhancing production of phenolic compounds production and antioxidants activity in callus cultures of Nepeta binaloudensis jamzad (Lamiaceae). Iran. J. Biotechnol. 2020, 18, 47–55. [Google Scholar] [CrossRef]
- Indriani, R.; Prihastanti, E.; Budihastuti, R.; Nurchayati, Y. Effect of subculture frequency toward growth and carotenoid content from tomato (Lycopersicon esculentum Mill.) Callus. J. Biodjati 2020, 5, 303–315. [Google Scholar] [CrossRef]
- Wahyuni, D.K.; Rahayu, S.; Zaidan, A.H.; Ekasari, W.; Prasongsuk, S.; Purnobasuki, H. Growth, secondary metabolite production, and in vitro antiplasmodial activity of Sonchus arvensis L. callus under Dolomite [CaMg(CO3)2] Treatment. PLoS ONE 2021, 16, e0254804. [Google Scholar] [CrossRef]
- Wahyuni, D.K.; Huda, A.; Faizah, S.; Purnobasuki, H.; Wardojo, B.P.E. Effects of light, sucrose concentration and repetitive subculture on callus growth and medically important production in Justicia gendarussa Burm.f. Biotechnol. Rep. 2020, 27, e00473. [Google Scholar] [CrossRef]
- Maemunah; Yusuf, R.; Samudin, S.; Yusran; Hawalina; Rini, N.S. Initiation of Onion Callus (Allium Wakegiaraki) Varieties of Lembah Palu at various light intensities. IOP Conf. Ser. Earth Environ. Sci. 2019, 361, 102028. [Google Scholar] [CrossRef]
- Cambaz, E.; Çördük, N. Secondary metabolite production in callus culture of Verbascum scamandri murb. Acta Soc. Bot. Pol. 2023, 92, 1–11. [Google Scholar] [CrossRef]
- Rijhwani, N.; Bharty, R. In vitro antioxidant activity and total phenolic content of leaf extracts of Dalbergia sissoo (roxb.). Int. Res. J. Pharm. 2016, 7, 16–21. [Google Scholar] [CrossRef]
- Mustafina, F.U.; kizi Jamalova, D.N.K.; Zarekarizi, A.R.; kizi Juraeva, H.K.K.; ogli Khazratov, A.T.O.; Hoe Jin, K.H.; Sun, N.C.; Sung, L.M.; Jin, O.Y.; Tojibaev, K.S.; et al. Optimized microclonal propagation protocol and antioxidant activity of callus cultures from the endangered Ferula tadshikorum Pimenov (Apiaceae Lindl.). Plant Cell Tissue Organ. Cult. 2025, 161, 51. [Google Scholar] [CrossRef]
- Lee, J.E.; Jayakody, J.T.M.; Il Kim, J.; Jeong, J.W.; Choi, K.M.; Kim, T.S.; Seo, C.; Azimi, I.; Hyun, J.M.; Ryu, B.M. The influence of solvent choice on the extraction of bioactive compounds from Asteraceae: A comparative review. Foods 2024, 13, 3151. [Google Scholar] [CrossRef]
- Barreca, D. Mechanisms of plant antioxidants action. Plants 2021, 10, 35. [Google Scholar] [CrossRef] [PubMed]
- Chaturvedi, S.; Gupta, P. Functional components in extracts of Beta vulgaris (chukandar) parts for antioxidant effect and antiobesity potential with lipase inhibition. Food Biosci. 2021, 41, 100983. [Google Scholar] [CrossRef]
- Johnson, T.S.; Nair, S.; de Souza, A.; Hingorani, L. Dalbergia sisoo Roxb. Ex-DC.—A Monograph. Pharmacogn. Rev. 2025, 18, 137–150. [Google Scholar] [CrossRef]
- Mozirandi, W.; Tagwireyi, D.; Mukanganyama, S. Evaluation of antimicrobial activity of Chondrillasterol isolated from Vernonia adoensis (Asteraceae). BMC Complement. Altern. Med. 2019, 19, 249. [Google Scholar] [CrossRef]
- Herilala Rasoanaivo, L.; Wadouachi, A.; Gabriel Andriamalala, S.; Jeannot Bako Razafindrakoto, E.; Randimbivololona, F.; Tantely Andriamampianina, T.; Raharisololalao, A. Triterpenes and Steroids from the stem bark of Gambeya boiviniana Pierre. J. Pharmacogn. Phytochem. 2014, 3, 68–72. [Google Scholar]
- Bárány, E.; Lindberg, M.; Lodén, M. Unexpected skin barrier influence from nonionic emulsifiers. Int. J. Pharm. 2000, 195, 189–195. [Google Scholar] [CrossRef]
- He, J.; Huang, S.; Sun, X.; Han, L.; Chang, C.; Zhang, W.; Zhong, Q. Carvacrol loaded solid lipid nanoparticles of propylene glycol monopalmitate and glyceryl monostearate: Preparation, characterization, and synergistic antimicrobial activity. Nanomaterials 2019, 9, 1162. [Google Scholar] [CrossRef] [PubMed]
- Godara, P.; Dulara, B.K.; Barwer, N.; Chaudhary, N.S. Comparative GC-MS analysis of bioactive phytochemicals from different plant parts and callus of Leptadenia reticulata Wight and Arn. Pharmacogn. J. 2019, 11, 129–140. [Google Scholar] [CrossRef]
- Arora, S.; Kumar, G.; Meena, S. Gas Chromatography-Mass Spectroscopy analysis of root of an economically important plant, Cenchrus ciliaris L. from Thar Desert, Rajasthan (India). Asian J. Pharm. Clin. Res. 2017, 10, 64. [Google Scholar] [CrossRef]
- Dikici, S.; Yar, M.; Bullock, A.J.; Shepherd, J.; Roman, S.; Macneil, S. Developing wound dressings using 2-Deoxy-d-Ribose to induce angiogenesis as a backdoor route for stimulating the production of vascular endothelial growth factor. Int. J. Mol. Sci. 2021, 22, 11437. [Google Scholar] [CrossRef]
- Lestari, D.A.; Ramadhan, R.; Phuwapraisirisan, P.; Firdaus, Y.H.F.; Kurnia, I.T.; Hariyanto, N.A.; Suhartini, S.; Abdulgani, N.; Fariha, N.M.; Phontree, K.; et al. Phytochemicals, antidiabetic, and antioxidant activities of Syzygium polyanthum achieved by GC-MS Analysis, α-Glucosidase inhibition and kinetic mechanism along with a free radicals scavenging activities. Moroc. J. Chem. 2025, 13, 34–56. [Google Scholar] [CrossRef]
- Sansenya, S.; Mansalai, P.; Payaka, A.; Puttasoon, C.; Buddhakala, N.; Kongdin, M.; Chumanee, S. Ethyl α-D-Glucopyranoside the first report in rice and its inhibitor for acetylcholinesterase by in vitro, in silico and fluorescence analysis. Food Biosci. 2025, 68, 106641. [Google Scholar] [CrossRef]
- Khatun, M.S.; Mia, N.; Al Bashera, M.; Murad, M.A.; Zahan, R.; Parvin, S.; Akhtar, M.A. Evaluation of anti-inflammatory potential and GC-MS profiling of leaf extracts from Clerodendrum infortunatum L. J. Ethnopharmacol. 2024, 320, 117366. [Google Scholar] [CrossRef]
- Chakraborty, S.; Majumder, S.; Ghosh, A.; Bhattacharya, M. Comprehensive profiling of aroma imparting biomolecules in foliar extract of Hibiscus fragrans Roxburgh: A metabologenesis perspective. J. Biomol. Struct. Dyn. 2022, 40, 10345–10358. [Google Scholar] [CrossRef] [PubMed]
- Dalawai, D.; Murthy, H.N.; Dewir, Y.H.; Sebastian, J.K.; Nag, A. Phytochemical composition, bioactive compounds, and antioxidant properties of different parts of Andrographis macrobotrys Nees. Life 2023, 13, 1166. [Google Scholar] [CrossRef]
- Madhubala, M.; Santhi, G. Phytochemical and GC-MS analysis on leaves of selected medicinal plants in boraginaceae family Cordia dichotoma L. Pramana Res. J. 2019, 9, 689–707. [Google Scholar]
- Carta, G.; Murru, E.; Banni, S.; Manca, C. Palmitic acid: Physiological role, metabolism and nutritional implications. Front. Physiol. 2017, 8, 902. [Google Scholar] [CrossRef] [PubMed]
- Rautela, I.; Joshi, P.; Thapliyal, P.; Pant, M.; Dheer, P.; Bisht, S.; Sinha, V.B.; Sundriyal, S.; Sharma, M.D. Comparative GC-MS analysis of Euphorbia hirta and Euphorbia milli for therapeutic potential utilities. Plant Arch. 2020, 20, 3515–3522. [Google Scholar]
- Karakaya, G.; Türe, A.; Ercan, A.; Öncül, S.; Aytemir, M.D. Synthesis, computational molecular docking analysis and effectiveness on tyrosinase inhibition of kojic acid derivatives. Bioorg. Chem. 2019, 88, 102950. [Google Scholar] [CrossRef]
- Sato, T.; Tomizawa, M.; Segawa, S.; Matsuoka, M.; Aurues, T. Effect of 2,3-Dihydro-3,5-Dihydroxy-6-Methyl-4H-Pyran-4-One-containing lactic acid bacterial beverages on skin moisture: A randomized, double-blind, placebo-controlled, parallel study. J. Clin. Biochem. Nutr. 2025, 76, 195–201. [Google Scholar] [CrossRef] [PubMed]
- Ko, G.A.; Shrestha, S.; Cho, S.K. Sageretia thea fruit extracts rich in methyl linoleate and methyl linolenate downregulate melanogenesis via the Akt/GSK3β signaling pathway. Nutr. Res. Pr. 2018, 12, 3–12. [Google Scholar] [CrossRef] [PubMed]
- Huh, S.; Kim, Y.-S.; Jung, E.; Lim, J.; Jung, K.S.; Kim, M.-O.; Lee, J.; Park, D. Melanogenesis Inhibitory Effect of Fatty Acid Alkyl Esters Isolated from Oxalis triangularis. Biol. Pharm. Bull. 2010, 3, 1242–1245. [Google Scholar] [CrossRef] [PubMed]
- Ko, G.A.; Cho, S.K. Ethyl Linoleate inhibits α- MSH-induced melanogenesis through Akt/GSK3β/β-Catenin signal pathway. Korean J. Physiol. Pharmacol. 2018, 22, 53–61. [Google Scholar] [CrossRef]
- Raman, B.V.; Samuel, L.A.; Saradhi, M.P.; Rao, B.N.; Krishna, N.V.; Sudhakar, M.; Radhakrishnan, T.M. Antibacterial, antioxidant activity and GC-MS analysis of Eupatorium odoratum. Asian J. Pharm. Clin. Res. 2012, 5, 99–106. [Google Scholar]
- Bansal, Y.; Mujib, A.; Mamgain, J.; Syeed, R.; Mohsin, M.; Nafees, A.; Dewir, Y.H.; Mendler-Drienyovszki, N. Integrated GC-MS and UPLC-ESI-QTOF-MS based untargeted metabolomics analysis of in vitro raised tissues of Digitalis purpurea L. Front. Plant Sci. 2024, 15, 1433634. [Google Scholar] [CrossRef]
- Rajkumar, J.; Chandan, N.; Lio, P.; Shi, V. The skin barrier and moisturization: Function, disruption, and mechanisms of repair. Ski. Pharmacol. Physiol. 2023, 36, 174–185. [Google Scholar] [CrossRef]
- Sabre, H.M. Review: Medical benefits of stearic acid for skin and its role in treatment of some diseases. Int. Sci. Health J. 2024, 2, 82–87. [Google Scholar] [CrossRef]
- Pereira-Leite, C.; Bom, M.; Ribeiro, A.; Almeida, C.; Rosado, C. Exploring stearic-acid-based nanoparticles for skin applications—Focusing on stability and cosmetic benefits. Cosmetics 2023, 10, 99. [Google Scholar] [CrossRef]
- Lin, T.K.; Zhong, L.; Santiago, J.L. Anti-inflammatory and skin barrier repair effects of topical application of some plant oils. Int. J. Mol. Sci. 2018, 19, 70. [Google Scholar] [CrossRef]
- Gupta, V.; Tyagi, S.; Tripathi, R. Hexadecanoic acid methyl ester, a potent hepatoprotective compound in leaves of Pistia stratiotes L. Appl. Biol. Chem. J. 2023, 4, 118–120. [Google Scholar] [CrossRef]
- Konappa, N.; Udayashankar, A.C.; Krishnamurthy, S.; Pradeep, C.K.; Chowdappa, S.; Jogaiah, S. GC–MS analysis of phytoconstituents from Amomum nilgiricum and molecular docking interactions of bioactive serverogenin acetate with target proteins. Sci. Rep. 2020, 10, 16438. [Google Scholar] [CrossRef]
- Tabassum, S.; Ahmad, S.; ur Rehman Khan, K.; Ali, B.; Usman, F.; Jabeen, Q.; Sajid-ur-Rehman, M.; Ahmed, M.; Muhammad Zubair, H.; Alkazmi, L.; et al. Chemical profiling and evaluation of toxicological, antioxidant, anti-inflammatory, anti-nociceptive and tyrosinase inhibitory potential of Portulacaria afra using in-vitro, in-vivo and in-silico studies. Arab. J. Chem. 2023, 16, 104784. [Google Scholar] [CrossRef]
- Ibrahim, M.T.; Uzairu, A. Theoretical validation of some third-generation Epidermal Growth Factor Receptor (EGFR) inhibitors as Non-Small Cell Lung Cancer (NSCLC) drugs. Egypt. J. Basic. Appl. Sci. 2023, 10, 329–341. [Google Scholar] [CrossRef]
- Pecoraro, B.; Tutone, M.; Hoffman, E.; Hutter, V.; Almerico, A.M.; Traynor, M. Predicting skin permeability by means of computational approaches: Reliability and caveats in pharmaceutical studies. J. Chem. Inf. Model. 2019, 59, 1759–1771. [Google Scholar] [CrossRef] [PubMed]
- El-Sharkawy, R.M.; El-Hadary, A.E.; Essawy, H.S.; El-Sayed, A.S.A. Rutin of Moringa oleifera as a potential inhibitor to Agaricus bisporus tyrosinase as revealed from the Molecular Dynamics of inhibition. Sci. Rep. 2024, 14, 20131. [Google Scholar] [CrossRef] [PubMed]
- OréMaldonado, K.A.; Cuesta, S.A.; Mora, J.R.; Loroño, M.A.; Paz, J.L. Discovering new tyrosinase inhibitors by using in silico modelling, Molecular Docking, and Molecular Dynamics. Pharmaceuticals 2025, 18, 418. [Google Scholar] [CrossRef] [PubMed]
- Ismaya, W.T.; Rozeboom, H.J.; Weijn, A.; Mes, J.J.; Fusetti, F.; Wichers, H.J.; Dijkstra, B.W. Crystal structure of Agaricus bisporus mushroom tyrosinase: Identity of the tetramer subunits and interaction with tropolone. Biochemistry 2011, 50, 5477–5486. [Google Scholar] [CrossRef]
- Pundir, H.; Joshi, T.; Pant, M.; Bhat, S.; Pandey, J.; Chandra, S.; Tamta, S. Identification of SARS-CoV-2 RNA dependent RNA polymerase inhibitors using Pharmacophore Modelling, Molecular Docking and Molecular Dynamics Simulation approaches. J. Biomol. Struct. Dyn. 2022, 40, 13366–13377. [Google Scholar] [CrossRef]
- Cheng, J.X.; Li, Y.Q.; Cai, J.; Zhang, C.F.; Akihisa, T.; Li, W.; Kikuchi, T.; Liu, W.Y.; Feng, F.; Zhang, J. Phenolic compounds from Ficus hispida L.f. as tyrosinase and melanin inhibitors: Biological evaluation, Molecular Docking, and Molecular Dynamics. J. Mol. Struct. 2021, 1244, 130951. [Google Scholar] [CrossRef]
- Murashige, T.; Skoog, F. A revised medium for rapid growth and bio assays with Tobacco tissue cultures. Physiol. Plant. 1962, 15, 473–497. [Google Scholar] [CrossRef]
- Ramamurthy, N.; Sa Vithramma, N. Shoot bud regeneration from leaf explants of Albizzia amara boiv. Indian J. Plant Physiol. 2003, 8, 372–376. [Google Scholar]
- Maqbool, M.; Ishtiaq, M.; Mazhar, M.W.; Casini, R.; Mahmoud, E.A.; Elansary, H.O. Enhancing bioactive metabolite production in Aerva sanguinolenta callus cultures through silver nanoparticle and salicylic acid elicitation. Sustainability 2023, 15, 10395. [Google Scholar] [CrossRef]
- Al-Dhabi, N.A.; Ponmurugan, K.; Maran Jeganathan, P. Development and validation of ultrasound-assisted solid-liquid extraction of phenolic compounds from waste spent coffee grounds. Ultrason. Sonochem. 2017, 34, 206–213. [Google Scholar] [CrossRef] [PubMed]
- Blois, M.S. Antioxidant determinations by the use of a stable free radical. Nature 1958, 181, 1199–1200. [Google Scholar] [CrossRef]
- Daina, A.; Michielin, O.; Zoete, V. SwissADME: A free web tool to evaluate pharmacokinetics, drug-likeness and medicinal chemistry friendliness of small molecules. Sci. Rep. 2017, 7, 42717. [Google Scholar] [CrossRef] [PubMed]
- Kim, S.; Chen, J.; Cheng, T.; Gindulyte, A.; He, J.; He, S.; Li, Q.; Shoemaker, B.A.; Thiessen, P.A.; Yu, B.; et al. PubChem 2025 Update. Nucleic Acids Res. 2025, 53, D1516–D1525. [Google Scholar] [CrossRef]
- Berman, H.M.; Westbrook, J.; Feng, Z.; Gilliland, G.; Bhat, T.N.; Weissig, H.; Shindyalov, I.N.; Bourne, P.E. The Protein Data Bank. Nucleic Acids Res. 2000, 28, 235–242. [Google Scholar] [CrossRef]
- Pettersen, E.F.; Goddard, T.D.; Huang, C.C.; Couch, G.S.; Greenblatt, D.M.; Meng, E.C.; Ferrin, T.E. UCSF Chimera—A visualization system for exploratory research and analysis. J. Comput. Chem. 2004, 25, 1605–1612. [Google Scholar] [CrossRef]
- Gupta, M.; Sharma, R.; Kumar, A. Docking techniques in pharmacology: How much promising? Comput. Biol. Chem. 2018, 76, 210–217. [Google Scholar] [CrossRef]
- Trott, O.; Olson, A.J. AutoDock Vina: Improving the speed and accuracy of docking with a new scoring function, efficient optimization, and multithreading. J. Comput. Chem. 2010, 31, 455–461. [Google Scholar] [CrossRef]
- Abraham, M.J.; Murtola, T.; Schulz, R.; Páll, S.; Smith, J.C.; Hess, B.; Lindah, E. Gromacs: High performance molecular simulations through multi-level parallelism from laptops to supercomputers. SoftwareX 2015, 1–2, 19–25. [Google Scholar] [CrossRef]
- Zoete, V.; Cuendet, M.A.; Grosdidier, A.; Michielin, O. SwissParam: A fast force field generation tool for small organic molecules. J. Comput. Chem. 2011, 32, 2359–2368. [Google Scholar] [CrossRef]
- Lindahl, E.; Bjelkmar, P.; Larsson, P.; Cuendet, M.A.; Hess, B. Implementation of the Charmm Force Field in GROMACS: Analysis of protein stability effects from correction maps, virtual interaction sites, and water models. J. Chem. Theory Comput. 2010, 6, 459–466. [Google Scholar] [CrossRef] [PubMed]
- Vijh, D.; Gupta, P. GC-MS analysis, molecular docking, and pharmacokinetic studies on Dalbergia sissoo barks extracts for compounds with anti-diabetic potential. Sci. Rep. 2024, 14, 24936. [Google Scholar] [CrossRef] [PubMed]
- Lemkul, J. From Proteins to Perturbed Hamiltonians: A Suite of Tutorials for the GROMACS-2018 Molecular Simulation Package [Article v1.0]. Living J. Comput. Mol. Sci. 2019, 1, 5068. [Google Scholar] [CrossRef]

| Compound Name | MF | MW (g/mol) | Peak Area % | Biological Activities | ||||
|---|---|---|---|---|---|---|---|---|
| LE | 20DC | 20DC1 | 20DC2 | 20DC3 | ||||
| Chondrillasterol | C29H48O | 412.7 | 1.57 | 4.00 | 4.16 | 2.57 | - | Antimicrobial, Anti-inflammatory, Antioxidant [47,48] |
| Glyceryl palmitate | C19H38O4 | 330.5 | - | - | - | 1.77 | - | Emulsifier, skin conditioning agent [49,50] |
| 7,9-Di-tert-butyl-1-oxaspiro (4,5) deca-6,9-diene-2,8-dione | C17H24O3 | 276.4 | 1.05 | 3.21 | 3.17 | 3.51 | 2.53 | Antineoplastic, Antimicrobial, Antiviral [51,52] |
| D-Ribose, 2-deoxy-bis (thioheptyl)-dithioacetal | C19H40O3S2 | 380.7 | - | 10.79 | 13.08 | 15.74 | - | Antioxidant, Antimicrobial, Stimulate angiogenesis and wound healing [53] |
| Stearic acid | C18H36O2 | 284.5 | - | 0.82 | - | - | - | Antifungal, Antitumor, Antibacterial, Anticancer [51,52] |
| Ethyl glucoside | C8H16O6 | 208.21 | - | 7.60 | 13.94 | 20.67 | - | Antioxidant, antimicrobial, Anti-inflammatory [54,55] |
| Methyl palmitate | C17H34O2 | 270.5 | - | 0.48 | 0.40 | 0.65 | - | Anti-Inflammatory, Antioxidant, Antitumor, immunostimulant, Antimicrobial [56,57,58] |
| Methyl α-d-galactopyranoside | C7H14O6 | 194.18 | - | - | - | - | 18.83 | * |
| Isopropyl myristate | C17H34O2 | 270.5 | - | 2.15 | 1.76 | 4.64 | 2.26 | Antioxidant, Antimicrobial, emollient. [51,52] |
| n-Hexadecanoic acid | C16H32O2 | 256.42 | 1.67 | 5.75 | 5.86 | 2.90 | 0.77 | Anti-inflammatory, Antioxidant, hypocholesterolemic, nematicide, pesticide, anti-androgenic flavor, hemolytic [59,60,61] |
| 1-Butyl-Cyclohexanol | C10H20O | 156.26 | 0.16 | 0.36 | - | - | 0.42 | Anti-inflammatory, Antioxidant [58] |
| 4h-pyran-4-one, 2,3-dihydro-3,5-dihydroxy-6-methyl- | C6H8O4 | 144.12 | - | 8.15 | 6.23 | 7.19 | - | Antioxidant, Antidiabetic, Antimicrobial, Anti-inflammatory [62,63] |
| Methyl linolenate | C19H32O2 | 292.5 | 0.39 | 0.55 | 0.37 | 0.59 | 0.17 | Anti-inflammatory, Anticancer, Anti histaminic, Anti-melanogenesis Antioxidant [64,65] |
| Ethyl linoleate | C20H36O2 | 308.5 | - | 0.66 | 1.11 | 0.35 | 0.27 | Anti-melanogenesis Antioxidant [65,66] |
| Phytol | C20H40O | 296.5 | 7.22 | 1.09 | 1.14 | 2.13 | 0.92 | Antimicrobial, Anticancer, Anti-inflammatory, Anti-diuretic, immunostimulatory, Antidiabetic [51,58,67] |
| Compound Name | PubChem ID | Molecular Weight (<500) | Number of Rotatable Bonds | HBA | HBD | M Log P | Log Kp (cm/s) | Number of Violations | Drug Likeness |
|---|---|---|---|---|---|---|---|---|---|
| Chondrillasterol | 5283663 | 412.69 | 5 | 1 | 1 | 6.62 | −2.92 | 1 | Yes |
| Glyceryl palmitate (Monopalmitin) | 14900 | 330.5 | 18 | 4 | 2 | 3.18 | −3.82 | 0 | Yes |
| 7,9-Di-tert-butyl-1-oxaspiro(4,5)deca-6,9-diene-2,8-dione | 545303 | 276.37 | 2 | 3 | 0 | 2.87 | −5.28 | 0 | Yes |
| D-Ribose, 2-deoxy-bis(thioheptyl)-dithioacetal | 575898 | 380.65 | 18 | 3 | 3 | 3.36 | −4.45 | 0 | Yes |
| Stearic acid | 5281 | 284.48 | 16 | 2 | 1 | 4.67 | −2.19 | 1 | Yes |
| Ethyl glucoside | 91694274 | 208.21 | 3 | 6 | 4 | −2.07 | −9.19 | 0 | Yes |
| Methyl palmitate | 8181 | 270.45 | 15 | 2 | 0 | 4.44 | −2.71 | 1 | Yes |
| Methyl α-d-galactopyranoside | 76935 | 194.18 | 2 | 6 | 4 | −2.4 | −9.37 | 0 | Yes |
| Isopropyl myristate | 8042 | 270.45 | 14 | 2 | 0 | 4.44 | −2.83 | 1 | Yes |
| n-Hexadecanoic acid | 985 | 256.42 | 14 | 2 | 1 | 4.19 | −2.77 | 1 | Yes |
| 1-Butyl-Cyclohexanol | 138505 | 156.26 | 3 | 1 | 1 | 2.45 | −5.15 | 0 | Yes |
| 4H-pyran-4-one, 2,3-dihydro-3,5-dihydroxy-6-methyl- | 119838 | 144.12 | 0 | 4 | 2 | −1.77 | −7.44 | 0 | Yes |
| Methyl linolenate | 5319706 | 292.5 | 14 | 2 | 0 | −1.77 | −7.44 | 0 | Yes |
| Ethyl linoleate | 5282184 | 308.5 | 16 | 2 | 0 | −1.77 | −7.44 | 0 | Yes |
| Phytol | 5280435 | 296.5 | 13 | 1 | 1 | 5.25 | −2.29 | 1 | Yes |
| Compound Name | Binding Affinity (kcal/mol) | No. of H-Bonds | Residue Involved In | ||
|---|---|---|---|---|---|
| H-Bond | Vander Waals | Pi-Alkyl Alkyl | |||
| Chondrillasterol | −8.7 | 0 | - | Val276, Leu275, Ser282, Gly190, Asp191, Glu189, Phe188, Lys79, Thr187 | Pro277, Pro284, Phe192, His285, Leu63, Tyr65 |
| Glyceryl palmitate (Monopalmitin) | −7.5 | 0 | - | Asn230, Gly223, Gly216, Ala215, Tyr201, Gly212, Asp269, Asn209, Met213 | Trp227, Pro270, Ala220 |
| 7,9-Di-tert-butyl-1-oxaspiro(4,5)deca-6,9-diene-2,8-dione | −7.3 | 2 | Lys379, Asp357 | Glu356, Asp312, Gln307, Thr308 | Tyr311, Trp358, Lys376 |
| D-Ribose, 2-deoxy-bis(thioheptyl)-dithioacetal | −6.8 | 1 | Asp30 | Asn29, Ala122, Glu123, Gln126 | Lys31, Ala127, Phe32 |
| Stearic acid | −6.8 | 1 | Ala323 | Thr261, Asn260, Met257, His 85, Asn81, Glu322, Thr324, Ala80 | Phe264, His244, Val283, Val248 |
| Ethyl glucoside | −6.4 | 0 | - | Thr308, Gln307, Tyr311, Asp312, Lys376, Glu356, Asp357, Lys379 | Trp358 |
| Methyl palmitate | −6.4 | 2 | Asn81, Ala323 | Ala80, Thr324, Glu322, Met257, Asn260, Thr261 | Val283, Phe264, His244, Val248, His85 |
| Methyl α-d-galactopyranoside | −6.3 | 2 | Gln307, Gln307 | Trp358, Lys379, Asp357, Glu356, Thr308, Tyr311, Asp312, Val313, Tyr314 | - |
| Isopropyl myristate | −6.3 | 0 | - | Tyr201, Gly216, Ala220, Thr261, Asn253, Asn230 | Leu265, Pro270, Phe224, Trp227 |
| n-Hexadecanoic acid | −6.1 | 1 | Asn230 | Tyr201, Gly216, Thr261, Ala252, Asn253 | Leu265, Pro270, Phe224, Trp227, Ala220 |
| Kojic acid * | −5.9 | 2 | His85, His259 | Ser282, Phe264, Gly281, Met280, Asn260, His61, Phe292, His296, His94 | Ala286 |
| Protein/Protein–Ligand Complex | Average RMSD (nm) | Average Rg (nm) |
|---|---|---|
| 2Y9X | 0.1591 ± 0.02 | 2.071 ± 0.01 |
| 2Y9X-Isopropyl myristate | 0.1398 ± 0.02 | 2.063 ± 0.01 |
| 2Y9X-n-Hexadecanoic acid | 0.1737 ± 0.02 | 2.071 ± 0.01 |
| 2Y9X-7,9-Di-tert-butyl-1-oxaspiro (4,5) deca-6,9-diene-2,8-dione | 0.1567 ± 0.02 | 2.060 ± 0.01 |
| 2Y9X-Chondrillasterol | 0.1523 ± 0.01 | 2.066 ± 0.01 |
| 2Y9X-D-Ribose, 2-deoxy-bis(thioheptyl)-dithioacetal | 0.1771 ± 0.02 | 2.072 ± 0.01 |
| 2Y9X-Ethyl glucoside | 0.1859 ± 0.03 | 2.078 ± 0.01 |
| 2Y9X-Glyceryl palmitate | 0.1883 ± 0.03 | 2.076 ± 0.01 |
| 2Y9X-Methyl palmitate | 0.1732 ± 0.02 | 2.073 ± 0.01 |
| 2Y9X-Methyl α-d-galactopyranoside | 0.1726 ± 0.02 | 2.073 ± 0.01 |
| 2Y9X-Stearic acid | 0.1626 ± 0.02 | 2.071 ± 0.01 |
| 2Y9X-Kojic acid (Standard) | 0.1627 ± 0.02 | 2.069 ± 0.01 |
Disclaimer/Publisher’s Note: The statements, opinions and data contained in all publications are solely those of the individual author(s) and contributor(s) and not of MDPI and/or the editor(s). MDPI and/or the editor(s) disclaim responsibility for any injury to people or property resulting from any ideas, methods, instructions or products referred to in the content. |
© 2025 by the authors. Licensee MDPI, Basel, Switzerland. This article is an open access article distributed under the terms and conditions of the Creative Commons Attribution (CC BY) license (https://creativecommons.org/licenses/by/4.0/).
Share and Cite
Jyotsana; Gupta, P. Establishment of Callus Cultures from Dalbergia sissoo Leaf Explants for Production of Skin Therapeutics: An In Vitro and In Silico Study. Molecules 2025, 30, 3531. https://doi.org/10.3390/molecules30173531
Jyotsana, Gupta P. Establishment of Callus Cultures from Dalbergia sissoo Leaf Explants for Production of Skin Therapeutics: An In Vitro and In Silico Study. Molecules. 2025; 30(17):3531. https://doi.org/10.3390/molecules30173531
Chicago/Turabian StyleJyotsana, and Promila Gupta. 2025. "Establishment of Callus Cultures from Dalbergia sissoo Leaf Explants for Production of Skin Therapeutics: An In Vitro and In Silico Study" Molecules 30, no. 17: 3531. https://doi.org/10.3390/molecules30173531
APA StyleJyotsana, & Gupta, P. (2025). Establishment of Callus Cultures from Dalbergia sissoo Leaf Explants for Production of Skin Therapeutics: An In Vitro and In Silico Study. Molecules, 30(17), 3531. https://doi.org/10.3390/molecules30173531

